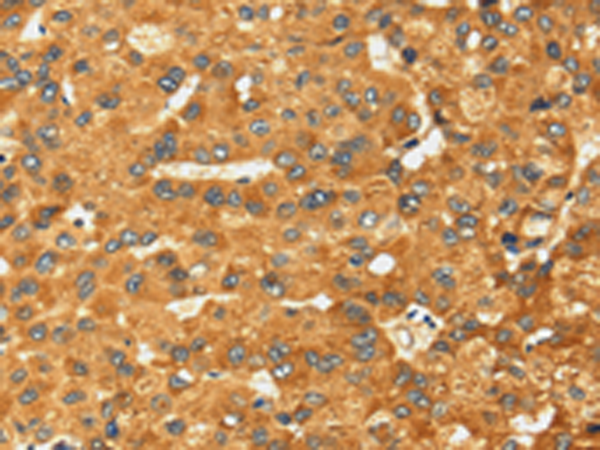
一抗

中文名稱:兔抗RFFL多克隆抗體
英文名稱: Anti-RFFL rabbit polyclonal antibody
別 名: CARP2; FRING; CARP-2; RNF189; RNF34L; RIFIFYLIN
相關類別: 一抗
儲 存: 冷凍(-20℃)
宿 主: Rabbit
抗 原: RFFL
反應種屬: Human, Mouse, Rat
標記物: Unconjugate
克隆類型: rabbit polyclonal
技術規(guī)格
|
IHC Recommend dilution: |
25-100 |
|
IHC positive control: |
Human liver cancer |
|
ELISA Recommended dilution: |
2000-5000 |
|
SwissProt: |
Q8WZ73 |
|
Synonyms: |
CARP2; FRING; CARP-2; RNF189; RNF34L; RIFIFYLIN |
|
Full name: |
ring finger and FYVE-like domain containing E3 ubiquitin protein ligase |
|
Immunogen: |
Fusion protein of human RFFL |
|
Name of antibody: |
RFFL |
|
Applications: |
ELISA, IHC |
|
Background: |
E3 ubiquitin-protein ligase that regulates several biological processes through the ubiquitin-mediated proteasomal degradation of various target proteins. Mediates 'Lys-48'-linked polyubiquitination of PRR5L and its subsequent proteasomal degradation thereby indirectly regulating cell migration through the mTORC2 complex. Also ubiquitinates the caspases CASP8 and CASP10, promoting their proteasomal degradation, to negatively regulate apoptosis downstream of death domain receptors. Also negatively regulates the tumor necrosis factor-mediated signaling pathway through targeting of RIPK1 to ubiquitin-mediated proteasomal degradation. |

 購物車
購物車 幫助
幫助
 021-54845833/15800441009
021-54845833/15800441009